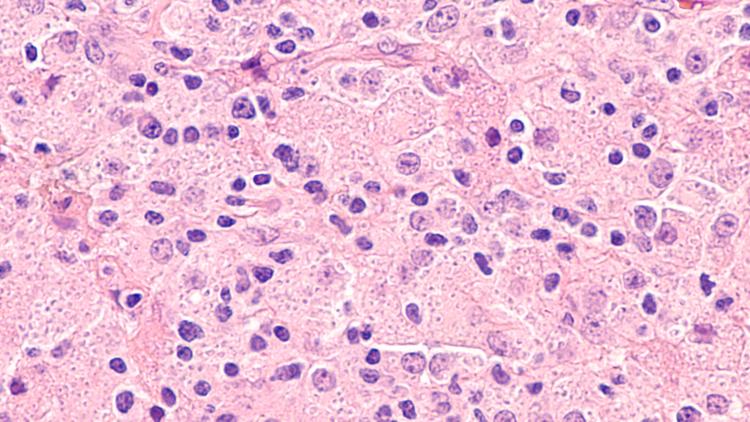
Preditores de mortalidade em pacientes com HIV e histoplasmose disseminada

Saúde
23 dezembro 2025|

Saúde
22 dezembro 2025|

Infectologia
19 dezembro 2025|

Saúde
19 dezembro 2025|

Infectologia
18 dezembro 2025|

Infectologia
15 dezembro 2025|

Saúde
08 dezembro 2025|

Saúde
03 dezembro 2025|

Pediatria
20 maio 2024|3 min.

Pediatria
9 dezembro 2020|3 min.

Medicina de Família
13 maio 2024|7 min.
Infectologia
19 fevereiro 2025|4 min.